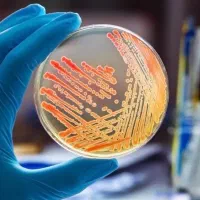
سمینار رایگان میکروبشناسی آزمایشگاه (ظرفیت محدود)

کارتخوان های سالم
نیم ساعت پیش

وباپلیکیشن یا PWA دیوار سرویسی است که نصب آن، استفاده از دیوار را بدون نیاز به دانلود اپلیکیشن و بهروزرسانی و تنها با کلیک روی آیکون آن فراهم میکند. در نسخهٔ وباپلیکیشن نیازی به دانلود و بهروزرسانی نیست و کاربران iOS و اندروید با دسترسی به آیکون اپلیکیشن در کنار سایر اپهای موبایل خود میتوانند از آن استفاده کنند.
۱. در نوار پایین روی دکمهٔ share بزنید.
۲. در منوی باز شده، گزینهٔ Add to home screen را انتخاب کنید.
۳. در قسمت بالا روی دکمهٔ Add بزنید.